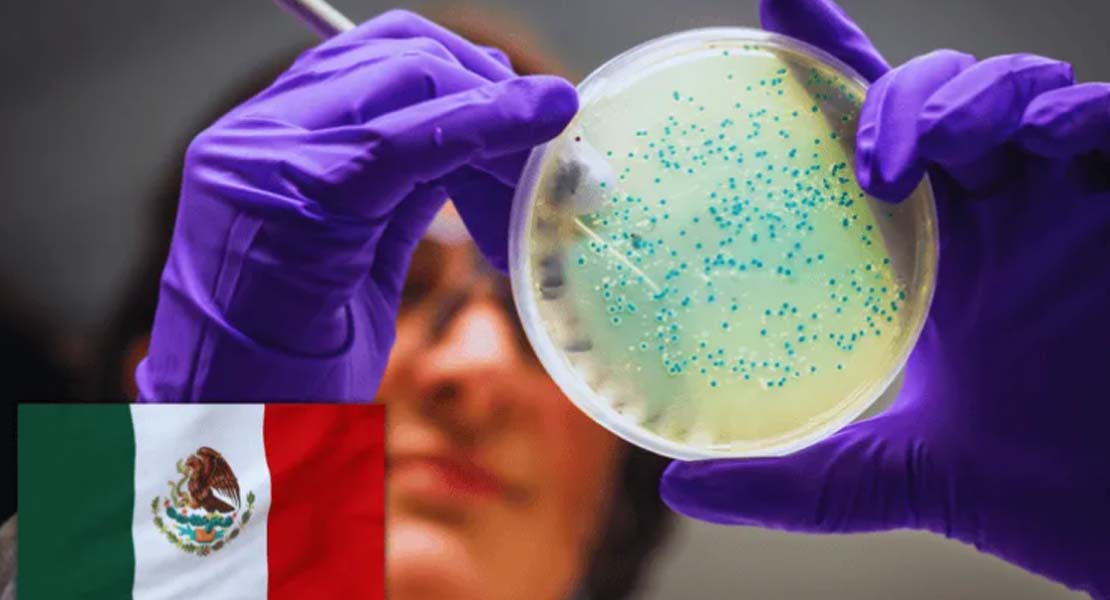

- Luis González Placencia, titular de la Anuies, advierte que la falta de estabilidad para siete de cada diez académicos frena el desarrollo científico de México
Ciudad de México.- Sin estabilidad laboral para el 70% de los académicos en México, el avance científico del país agoniza. Esta precariedad no solo vulnera derechos básicos, sino que frena la innovación soberana y el desarrollo social, convirtiendo la lucha por condiciones dignas en una batalla urgente por el futuro de la nación.
Ciudad de México.- Sin estabilidad laboral para el 70% de los académicos en México, el avance científico del país agoniza. Esta precariedad no solo vulnera derechos básicos, sino que frena la innovación soberana y el desarrollo social, convirtiendo la lucha por condiciones dignas en una batalla urgente por el futuro de la nación.
El colapso del modelo laboral: 70% del profesorado en la incertidumbre
Más del 70% del personal académico en México trabaja bajo esquemas de asignatura, sin estabilidad laboral ni condiciones para investigar, una precariedad que limita el desarrollo científico del país y que obliga a replantear de fondo el modelo laboral en el sector, advirtió Luis González Placencia, secretario general ejecutivo de la Asociación Nacional de Universidades e Instituciones de Educación Superior (Anuies).
Durante la inauguración del 5º Encuentro Internacional de Trabajadoras/es Científicos y el 8º Foro Latinoamericano del sector, el funcionario subrayó la urgencia de transformar las condiciones laborales de investigadores y docentes bajo una premisa central: «no hay ciencia sin científicos».
En su intervención remota, desde el panel inaugural realizado en el Centro de Investigaciones Biológicas del Noroeste, en Baja California Sur, señaló que la precariedad laboral no solo afecta a quienes integran la comunidad científica, sino que compromete la capacidad del país para generar conocimiento, innovación y desarrollo soberano.
Ante representantes de países como Argentina, Bolivia, Colombia, Brasil, Ecuador, Perú y Guatemala, González Placencia demandó transitar hacia modelos de contratación que garanticen estabilidad laboral, seguridad social y condiciones dignas para el trabajo académico.
Ciencia como bien público: El pliego de demandas de la Anuies
Entre las principales exigencias planteadas por la Anuies destacan la creación de esquemas de retiro digno, mecanismos de relevo generacional con certidumbre para jóvenes investigadores y el cierre de brechas de género, especialmente en áreas STEM y en cargos directivos, así como la garantía de espacios libres de acoso.
El titular del organismo insistió en que la ciencia debe ser reconocida como un bien público y un derecho humano, no como una actividad aislada, y sostuvo que mejorar las condiciones laborales del sector es clave para impulsar su papel como motor de transformación social.
En ese sentido, planteó que la agenda científica debe alinearse con desafíos como la sostenibilidad ambiental, la lucha contra el cambio climático y el uso ético de la inteligencia artificial, con un enfoque incluyente.
Asimismo, abogó por una internacionalización solidaria en América Latina, basada en el diálogo horizontal y el reconocimiento de las epistemologías propias de la región, en contraste con la adopción automática de modelos anglosajones.
«La defensa de los derechos de la comunidad científica es la defensa del futuro de nuestras naciones», afirmó.
